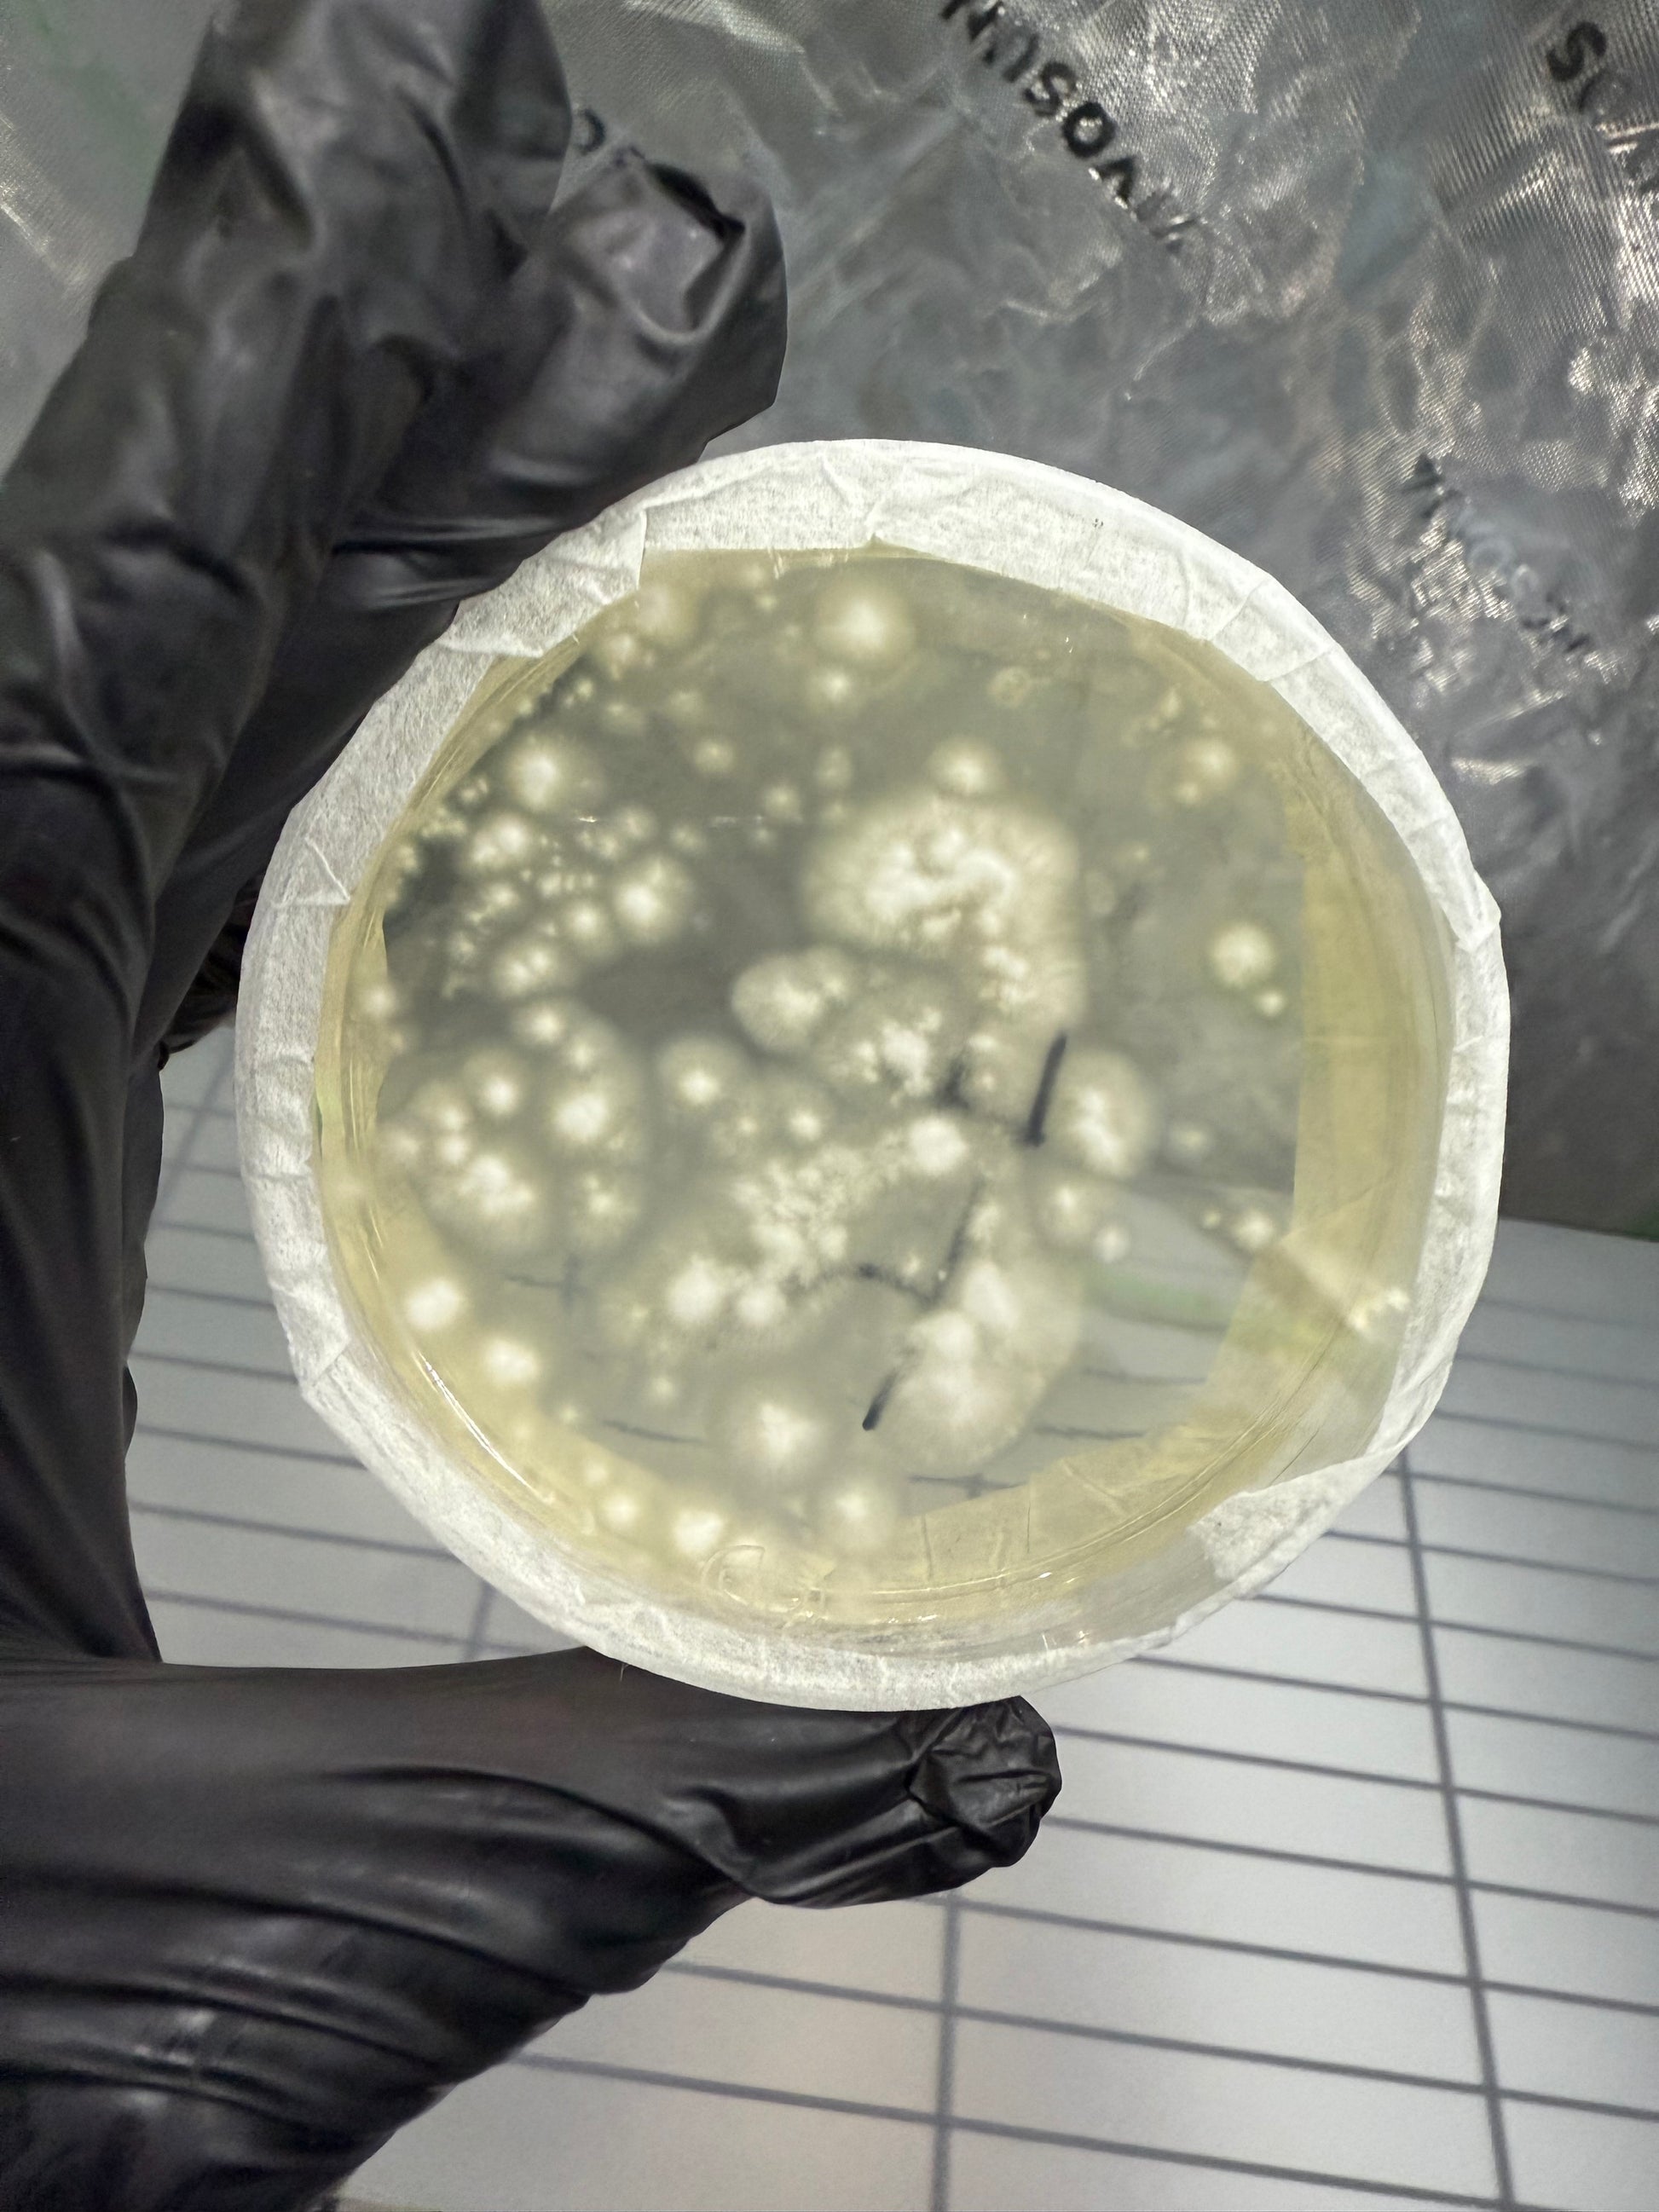

1
/
of
3
psyco myco supplies
Colonized Agar Plate
Colonized Agar Plate
Regular price
$24.99 USD
Regular price
$29.99 USD
Sale price
$24.99 USD
Unit price
/
per
Couldn't load pickup availability
Get a closer look at microbial life with our Colonized Agar Plate. This agar plate is specifically designed for growing and observing colonies of bacteria, fungi, and other microorganisms. Perfect for laboratory use, research, or educational purposes. Expand your understanding of the microscopic world with our Colonized Agar Plate.
Share